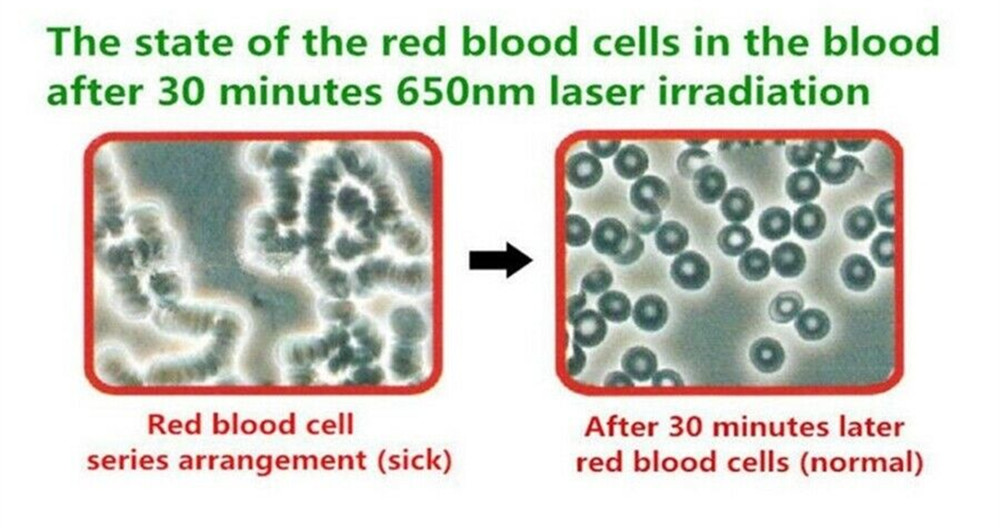

What is the indications of the COZING-WS11C with All accessories?
- COZING-11C +ear diode treatment range :Otitis media, deafness, tinnitus, Meniere's syndrome
- COZING-11C +throat diode treatment range : snore, pharyngitis, mouth or tongue skin ulcer
- COZING-11C +nasal diode treatment range : Rhinitis, allergic rhinitis, acute rhinitis, chronic rhinitis, sinusitis and nasal polyps
- COZING-11C +surface diode treatment range : pain relief, Knee arthritis, Rheumatoid Arthritis, Athletic system injuries, Soft tissue injuries,Diminish inflammations, Wounds & Ulcers, Osteoarthritis, Acupuncture, Rehabilitation therapy, Joint & soft tissue injuries, Neck & Back, arthritis ,Strains & sprains, Frozen shoulder, Tennis/Golfer Elbow , Sciatica , Knee/ foot pain, Achilles Tendonitis
- Wrist probe treatment range:hypertension,diabetes ,hyperviscosity, hyperlipidemia, hyperlipidemia, ischemic heart and cerebrovascular disease caused by cardiovascular and cerebrovascular diseases.

How does the COZING-WS11C with All accessories to reduce Hyperlipidemia naturally ?
Through the irradiation of low-intensity laser generated by COZING-WS11C , it can convert optical energy into biological internal energy to regulate environment of the body, reduce blood viscosity, enhance the deformability of erythrocyte and oxygen carrying capacity, improving micro-circulation, activate of various enzymes, and stimulate the adrenal cortex function, so that the glucocorticoids is increased, it makes a reduction of synthesis of cholesterol lipoprotein in the liver, accelerating the dissolution of triglyceride, to speed up the decomposition of lipoproteins.

How does the COZING-WS11C with All accessories to treat Hypertension?
The laser wrist watch is adopte eleven 650nm low-level laser, when cold laser watch irradiates defined acupuncture points on the wrist (radial artery, Antigenic point and nasal cavity appoint), the energy light can be absorbed by cells, to stimulates protein synthesis, help to clean blood vessel waste, improve oxygen-carrying capacity of red blood cells, accelerate blood circulation & human metabolism, reduce high blood viscosity, blood sugar, blood fat, blood pressure, repair damaged nasal mucous and cure rhinitis at the same time.
How does the COZING-WS11C with All accessories to treat Hyperviscosity?
The semiconductor laser therapeutic apparatus adopts low-intensity laser to irradiate the blood, polysaccharide lipoproteins with poor permeability and many other medium molecular substances adsorbed around the erythrocytes, thus increase the flexibility and permeability of membrane and restore the normal potential of membrane surface, to avoid the aggregation of red cells, thereby improving blood viscosity.

How does the COZING-WS11C with All accessories to treat Tinnitus?
- The prevailing opinion is that the respiratory chain plays a central role in the effect induced by laser therapy. Laser energy in the red and near infrared light spectrum is capable of penetrating tissue. It stimulates mitochondria in the cells to produce energy through the production of adenosine triphosphate (ATP).
- Mitochondria is the power supplies of all cells; they metabolise fuel and produce energy for the cell in the form of ATP. It has been reported that LLLT irradiation increases the production of ATP.
- Increased ATP production may lead to enhanced cell metabolism, promoting the damage recovery process, returning cells to a healthy state and reversing many degenerative conditions.
- For ear disorders, low-level laser has been reported to alter the collagen organisation within the cochlea,especially within the basilar membrane.
- Also, LLLT has a beneficial effect on the recovery of cochlear hair cells after acute hair cell loss, increases cell proliferation, synthesis of ATP and collagen, releases of growth factors, promotes local blood flow in the inner ear and activates repair mechanisms in the inner ear through photochemical and photophysical stimulation of the hair cell mitochondria.

How does the COZING-WS11C with All accessories to treat rhinitis?
The Rhinitis Therapeutic Instrument mainly adopts the special soft laser light (650nm) which can get through the nasal mucosa of the human body. The soft laser light is featured mild working rate and could be fully and safety absorbed by the nasal tissue of the human body. This kind of laser light has a special repair function to the nasal mucosa of the rhinitis patients. The repaired nasal mucosa could secrete antibacterial material including lysozyme as normal mucosa and restart the normal cleaning function of the swinging cilia on the nasal mucosa.

How does the COZING-WS11C with All accessories to treat oral ulcer?
Oral irritations such as traumatic ulcers, canker sores, and cold sores can be effectively treated with combined laser therapy.Lasers produce a coherent wavelength of red light, which encourages catalytic changes increasing the metabolism of reproducing epithelial and probabilistic cells: the cells involved in mucosal and epidermal wound healing.Most oral ulcers, such as caused by aphthous symptomatic, herpes, and traumatic episodes, will quickly heal when exposed to laser light in the 650nm (red) wavelength range. Even the AIDS caused tongue ulcer has excellent treatment efficiency.
How do the COZING-WS11C with All accessories to pain?
COZING laser therapy is a non-invasive pain management technique that uses low-level laser therapy to reduce pain and inflammation. It is most commonly used for pain related to arthritis or sciatica. It’s been used in Europe for pain management for decades and has recently been used in home health care.

Why we select radial artery laser surface irradiation?
- Radial artery is one of the superficial arteries, which is relatively superficial and close to heart, besides, it has greater blood flow volume, and the whole body blood would flow through the radial artery about 8 minutes (whole blood volume).
- Since the radial artery is superficial. It is easy to touch and locate, and runs parallel with the radial artery
- Therefore, laser is easy to irradiate blood by penetrating skin and vascular wall, so as to ensure the treatment effect.
- Moreover, in terms of wearing therapeutic apparatus,radial artery is more convenient for treatment.

Why Irradiation Neiguan Acupoint?
---Neiguan Acupoint can adjust the abnormal heart rate in a bidirectional way, so the high heart rate can be slowed down and the low heart rate can be accelerated.
---Neiguan Acupoint can increase the blood flow of coronary artery in acute myocardial ischemia.
---Neiguan acupoint can strengthen myocardial contractility and improve cardiac function.

Why Irradiation Nasal cavity?
---The location of nasal cavity is close to brain which is the center of human body.
---Abundant vessels and nerve systems are distributed under the nasal cavity.
---60% blood flow of nasal mucosa goes through arteries and vein, and blood goes through nasal cavity at around 3 minutes.

What is the Clinical test of the COZING-WS11C with All accessories?
- After about 30 mins irradiation treatment, blood red cells wil be activated, become single, active, health and normal.
- After about 30 days treatment, headache, dizziness, chest tightness, numbness and other symptoms will disappear.
- After about 3 months treatment, you can do blood detect, or CT detect, high blood pressure, high blood viscosity, high cholesterol will get back to a normal level.
What's the Characteristics of the COZING-WS11C with All accessories?
- Physical therapy with low level laser therapy , no side effect, no trauma
- Small size, easy to carry, it could be use at anywhere
- It`s adopt the non-invasive laser acupuncture, to ensure the treatment efficiency
- The treatment efficiency is around 90%
- Imported laser diode , to ensure the laser output quality and durable
- It could also connect to the ear treatment probe, oral&throat treatment probe and pain relief probe(that`s all the extra parts)
- The exterior shell is stainless steel, show the high class , and help the main device heat output.
- The wrist part shape is coordinate with the wrist shape, the humanized design.
- This technological has been proved,and got a CE certification.

What's the the COZING-WS11C with All accessories's patient groups?
- Suitable for serious cardiovascular and cerebrovascular diseases, some sensitive Physical
- Suitable for very bad physique crowds, very old people, over 70 year-old
- Suitable for normal old crowds, middle aged or aged people with Hypertension, hyperlipidemia, blood high viscosity,.
- Suitable for young or middle aged people, who has symptoms of sub-health status.
- For normal crowds, it 's better to use Mode 3, the right way.
package will including 1*main apparatus+1*nasal applicator+1*ear applicator+1*pain applicator+1*throat applicator+1*connection wire+1*adapter +1*manual book
Low Level Laser Acupuncture Therapy Device Home Remedies Lower High BP Naturally
- Product Code: COZING-WS11C-ALL
- Availability: In Stock
-
$439.00
- Ex Tax: $439.00
Tags: cold laser therapy device, laser acupuncture, blood pressure smart watch, laser therapy watch








